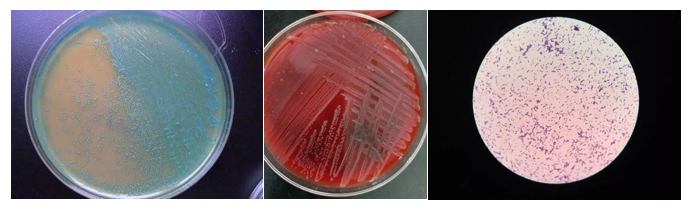

30岁的小静(化名),跟当代大多数大龄单身青年一样,不还房贷不养娃,日子过得潇洒自在。
每天下了班,也不去无效社交,就回家躺着刷剧吃吃喝喝。

那天周末她跟往常一样宅在家,午餐就是冰箱里的隔夜披萨,因为懒得加热,所以直接拿出披萨就啃。
没想到这一口披萨,就让她摊上“大祸”。
三天后,她莫名其妙头痛、肌肉酸痛,一开始以为是感冒,吃了颗止痛药就去睡了。
但一觉起来,症状不但没好转,头痛炸裂,还开始呕吐,脖子也变得僵硬。
察觉到不对劲的她当即打车到了医院,医生一听发病历程和症状后,隐隐不安——
可能是脑膜炎。
果然,一番检查下来,脑室已经有感染的表现,能看得出脑脊液分层了。
腰穿出来的脑脊液,也都是浑浊的脓液,一般正常的脑脊液是清水状。

经过多学科专家联合会诊,别无他法,脑膜炎发展为脑室炎了,只能做颅脑手术。
但就好比在结满蜘蛛网和霉菌的墙皮上做大扫除,要做到一尘不染,又不伤墙皮一分一毫,难度不言而喻。
不慎伤到脑室壁或血管,随时可能引发颅内大出血。

▲医生用脑室镜探查脑室的第一视角
整个脑室像“盘丝洞”
所幸,手术过程顺利,小静也在医院继续接受药物治疗。
话说回来,好好地,怎么吃了口隔夜披萨就摊上脑膜炎呢?
其实,是李斯特菌这个不怕冷的“冰箱杀手”在“搞鬼”。
壹
李斯特菌
不怕冷的"冰箱杀手"
李斯特菌,一种广泛存在于自然界中的菌株。这一引起食源性疾病暴发的主要病原菌,也是致命的食源性病原体之一,其致死率可达20%~50%。
▲李斯特菌平板菌落特征及镜下特征
(图源:“上海交通大学医学院附属仁济医院” 微信公众号)
其对各种环境(如低温、高盐、低pH、氧化应激等)的耐受性很强,4~10度是其最适宜的生长温度,可大肆繁殖,所以江湖人称“冰箱杀手”。
李斯特菌是一个大家族,其中,单核细胞增多性李斯特菌是唯一经常感染人类的李斯特菌种,且更常见发生在夏季。

这种条件致病菌可以通过被污染的食物,经过消化道、眼睛、破损的皮肤和黏膜,进入人体造成感染。
生奶源及其制品、冰激凌、生食的水果蔬菜、肉及肉制品、冷的熟食生食类、烟熏类海产等,都容易被李斯特菌污染。

更棘手的是,由于细菌可以在食品加工厂中繁殖并持续数年(有超过10年的案例),因此可能导致食品的间歇性污染。
贰
被李斯特菌感染有多危险
自1980年以来,大约有80例公认的李斯特菌病暴发,与其他食源性疾病相比,李斯特菌病很少见,但非常严重。
即使使用足够的抗生素治疗,该病的死亡率仍高达20%~ 30%。超过90%的李斯特菌病患在重症监护病房住院。

世界卫生组织估计,2010年全世界李斯特菌病使23150人患病,其中5463人死亡。
在美国,每年估计的李斯特菌病病例范围为1600~2500,其中260~500人死亡。
欧洲联盟2009年也报告了1645起李斯特菌病病例,估计有270人死亡。
人们常常因为直接吃了李斯特菌感染的食物,或者接触受污染的食物或触摸受污染的表面和器皿,然后不经意间将细菌从手传播到口腔中而感染。
病菌进入消化道后会穿透肠道黏膜,引起全身性感染。如果在怀孕期间发生感染,李斯特菌可通过胎盘传播到胎儿或者新生儿。
叁
这4类人群最容易中招
对于健康的成年人来说,李斯特菌致病力有限。但免疫力低下的人群,就要打起十二分精神了!
孕妇、婴儿、老人、肿瘤患者等免疫力低下人群,是李斯特菌的重点攻击对象。
01 孕妇
在怀孕期间,李斯特菌感染可能仅对母亲造成轻微的体征和症状,但是对胎儿可能是毁灭性的,可能导致流产、死产、早产或者威胁生命的新生儿感染(例如败血症、呼吸窘迫、肺炎和脑膜炎)。怀孕期间的李斯特菌病导致约20%的胎儿流产,约 3% 的新生儿死亡。
02 婴儿
新生儿可能在出生时或者出生后获得感染,出生第1周的感染常表现为脓毒症,而出生1周后常为脑膜炎。
03 老人、肿瘤患者等免疫力低下人群
其他免疫力低下的人群,可能会引起败血症、脑膜炎等,严重可致命。

▲图源:腾讯医典
肆
如何预防感染
首先,让我们认识一下常见的易受细菌污染的食物:
• 生肉
• 冷冻的肉酱
• 即食烟熏海鲜和生海鲜
• 准备或储存的沙拉
• 甜瓜、西瓜
• 生蔬菜
• 未经巴氏消毒的牛奶或未经巴氏消毒的牛奶制成的食品
• 某些加工食品,如加工后被污染的软奶酪,热狗和熟食肉
针对这些食物,再结合李斯特菌的生存"喜好",我们为大家总结了7个保命提醒:
01 一不吃
未经任何消毒处理的蔬菜和肉类(蛋类、肉类和海鲜时要保证熟透)。
02 二不吃
未经巴氏消毒的奶和乳酪,以及用它们制作的食品。
03 水果充分清洗
吃水果前洗干净,最好去皮食用。
04 生熟分开
食物放进冰箱前,密封包装,生熟分开。
05 检查包装
买即食食物时,检查食品包装密封是否完整。
06 加热彻底
从冰箱里拿出来的生冷食物,60摄氏度持续加热20分钟,或70摄氏度加热5分钟以上,再食用。
07 保持卫生
手、刀和砧板接触生食后要清洗干净,定期对冰箱进行彻底消毒。
要知道李斯特菌的“软肋”就是不耐热,巴氏灭菌、烧熟煮透这些简单的措施就能对付它。所以,只要记牢上面这7个提醒,一般它是不会来“贴贴”的。
本院医生亲诊
电话咨询
028-68760707